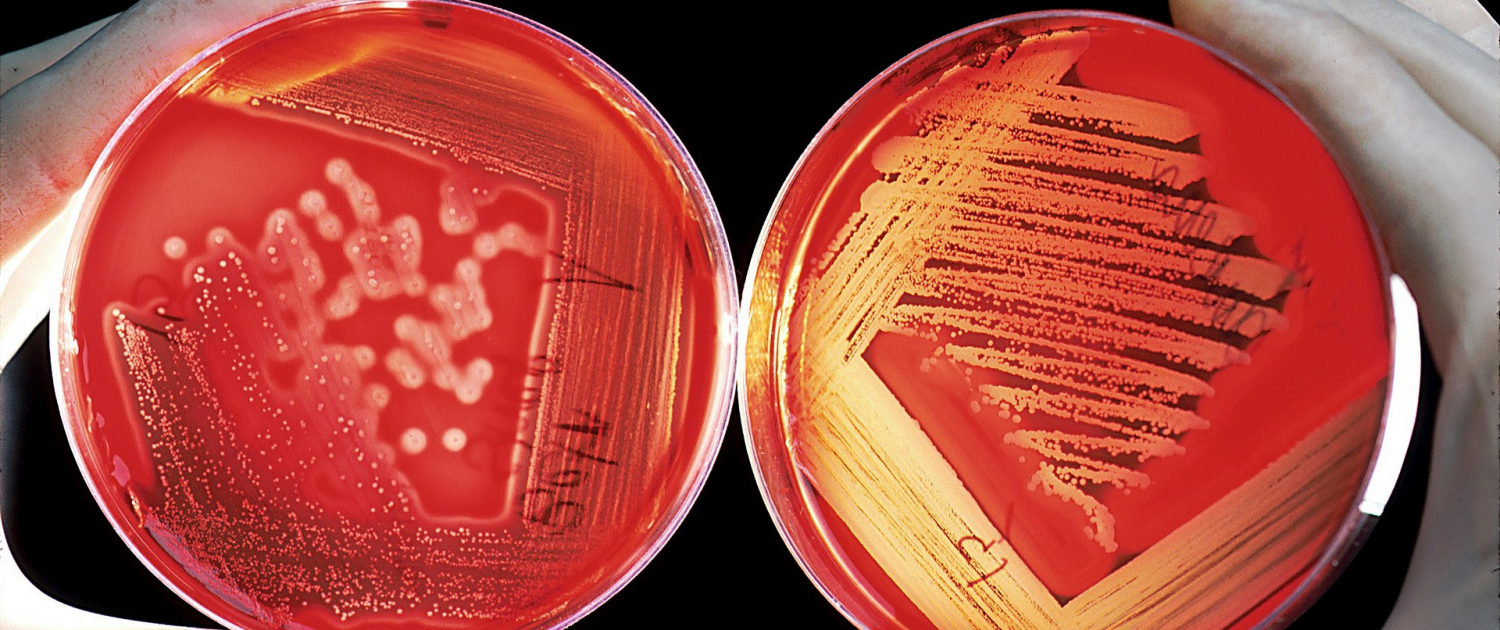

We use cookies on our website, our own and third party, to ensure proper functioning, improve your user experience, personalize content throughout this website, perform usage analysis, recommend content based on your preferences, display ads on other sites that may be of interest to you and facilitate interaction on social networks.
To learn more about cookies, partners, and how we use your data, to review your options or these operations for each partner, see our Cookie Policy.
By clicking "I accept", you accept all cookies and can browse the site with a more personalized experience.